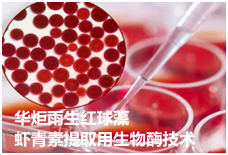

雨生红球藻虾青素提取用生物酶技术配方及方法
虾青素最早发现于虾蟹的外壳中,是目前自然界发现的最强大的天然抗氧化素。与其他抗氧化素相比,虾青素兼具脂溶性及水溶性,因此更易于被人体吸收。虾青素的抗氧化能力,是维生素C的6000倍;维生素E的500-1000倍;是辅酶Q10的800倍。因此虾青素被应用为保健品在市场发售,尤其是在抗衰老领域的表现,虾青素被称为超级维生素E。在虾青素的提取工艺中,其提取率与其破壁程度密切相关,目前大部分破壁处理均为单一的试剂破壁、研磨破壁或者超声破壁,无法对红球藻粉末进行较好的破壁分离,直接影响后续的提取效率;同时提取后的虾青素活性和提取过程中所受的温度和光照有着密切关系,一般温度大于55℃其活性就会降低,同时其活性也随着光照时长的增加而降低,这就会出现高提取率、低活性的情况发生,导致高活性的虾青素提取率不高,这样,就会增大较大的提取成本,以及虾青素的质量。
华炬新产品研究所技术咨询委员会科研人员现推荐一项雨生红球藻虾青素提取用生物酶技术配方及方法,该技术采用复合生物酶酶,由于雨生红球藻的细胞壁是有纤维素蛋白和果胶组成的网状结构,所以采用复合酶系可以有效瓦解植物细胞壁,提高生物细胞壁和细胞膜的通透性,加速细胞内容物的流出,特别是在一次破壁后的加入使用,可以对物理破损后的破损物质进行快速瓦解,由于研磨后无法使每个细胞破碎,但是雨生红球藻的大部分结构均被破坏,所以这时加入响应的酶进行酶解,可以事半功倍,不仅加大了整体溶出率,同时也为后序二次破壁提供了更加容易的破碎环境,进一步的保证了整体的溶出率,现将该雨生红球藻虾青素提取用生物酶技术配方及方法及实例介绍如下供研究参考:(341511 634525)
技术资料 请支付后查看;1、点击下面"查看详细"按钮提交订单并打开付款码,2、用手机微信扫描付款码完成付款即可查看!!!
200.00元
